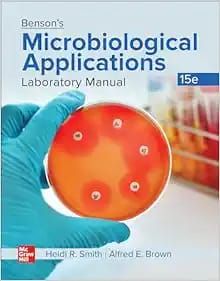
Microbiological Applications-Concise

Medical eBook House
Medical eBook House is the Best online medical books resource which serves medical professionals in providing Ebooks, video courses/ Lectures of all kinds in various languages on their demand at very reasonable prices.
Explore huge range of books of your medical specialty in below categories
Infectious Diseases, Microbiology & Immunology Books - Medical Textbooks & Laboratory Guides
Explore our comprehensive collection of microbiology and immunology books, featuring essential medical textbooks, laboratory manuals, and clinical references for healthcare professionals. Our expertly selected library covers fundamental microbiology principles, advanced immunology concepts, and practical laboratory techniques from leading medical publishers and renowned scientists.
What You'll Find:
- Medical Microbiology Textbooks
- Comprehensive guides covering bacteria, viruses, fungi, and parasites
- Clinical Immunology References
- In-depth resources on immune system function and disorders
- Laboratory Microbiology Manuals
- Practical guides for diagnostic testing and culture techniques
- Molecular Microbiology Books
- Advanced texts on genetic mechanisms and molecular diagnostics
- Immunopathology Guides
- Specialized resources on immune-mediated diseases and autoimmunity
- Vaccine Immunology Texts
- Comprehensive vaccination science and development resources
- Diagnostic Microbiology Atlases
- Visual guides for pathogen identification and laboratory diagnosis
Perfect For:
- Medical students studying microbiology and immunology
- Clinical laboratory scientists and technologists
- Microbiologists and immunology researchers
- Infectious disease specialists and pathologists
- Medical residents preparing for board examinations
- Public health professionals and epidemiologists
- Pharmaceutical researchers in vaccine development
Key Features:
- Latest editions with current research findings
- High-quality microscopic images and diagnostic photos
- Step-by-step laboratory protocols and procedures
- Clinical case studies and real-world applications
- Digital and print formats available
- Multilingual scientific resources
- Competitive academic and professional pricing
Specialized Topics Covered:
- Clinical bacteriology and virology
- Immunodeficiency disorders and testing
- Antimicrobial susceptibility testing
- Flow cytometry and immunoassays
- Molecular diagnostic techniques
- Vaccine development and immunization
- Hospital-acquired infection prevention
- Emerging pathogens and biodefense
Master the fundamentals of microbiology and immunology with our authoritative collection. From basic microbial biology to advanced immunological concepts, these resources provide the essential knowledge for laboratory practice, clinical diagnosis, research advancement, and medical education excellence."
Additional Hot Keywords to Search on our Store:
- Medical microbiology textbooks
- Clinical immunology books
- Laboratory microbiology guides
- Diagnostic microbiology references
- Immunology medical education
- Microbiology board review
- Clinical laboratory science books
- Immunopathology textbooks
- Molecular microbiology resources


I received my Ebooks within 15 min. Thank you!
It was great service, I will highly recommend all of my colleagues
La compran fue muy fácil y la entrega súper rápida. El libro esta muy bien. Buenas explicaciones y muy buen contenido. Recomiendo mucho este sitio para comprar.
Great and fast like always!
Excellent service, very easy payment, super fast delivery. Excellent book to review, clinical cases with explanation.
About us

Medical eBook House
+447555747230
Medical eBook House is the Best online medical books resource which serves medical professionals in providing Ebooks, video courses/ Lectures of all kinds in various languages on their demand at very reasonable prices.